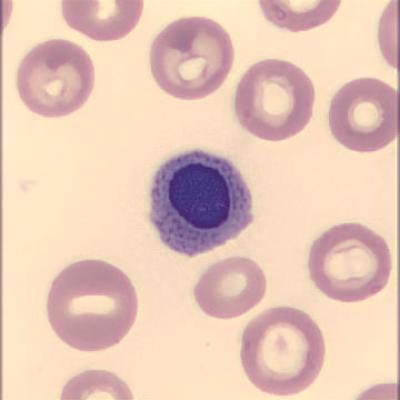
Normoblast Haema Riegler4
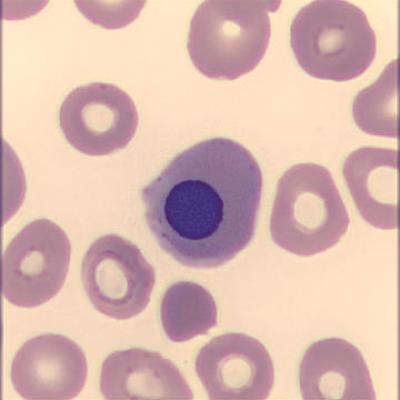
Normoblast Haema Riegler1
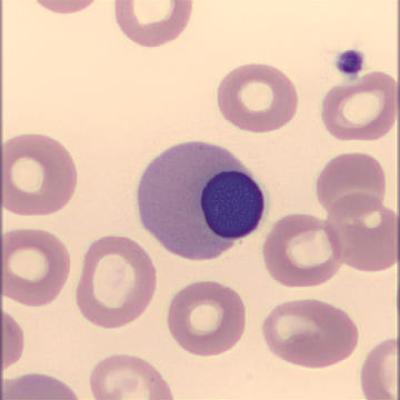
Normoblast Haema Riegler3
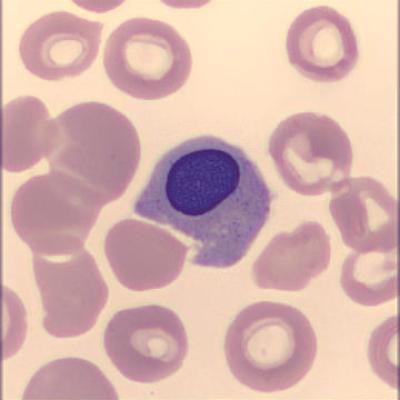
Normoblast Haema Riegler2

Schnellzugriff
Nimm Kontakt auf
Alexander Riegler, MPH, EMPH, BSc.
Lilienthalgasse 14/1
8020 Graz
Tel.: +43 664 423 36 24
Email: office@alexanderriegler.at
Support
Medizinische Anfragen
Es werden keine medizinschen Ratschläge gegeben. Wenden Sie sich bitte immer an den Arzt Ihres Vertrauens.
KI-Einsatz bei Texten
Texte auf dieser Webseite wurden teilweise mit KI erstellt, überarbeitet oder geprüft. Bitte prüfen Sie bei Unsicherheiten zusätzliche Quellen.